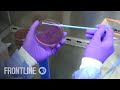

- Популярные видео
- Авто
- Видео-блоги
- ДТП, аварии
- Для маленьких
- Еда, напитки
- Животные
- Закон и право
- Знаменитости
- Игры
- Искусство
- Комедии
- Красота, мода
- Кулинария, рецепты
- Люди
- Мото
- Музыка
- Мультфильмы
- Наука, технологии
- Новости
- Образование
- Политика
- Праздники
- Приколы
- Природа
- Происшествия
- Путешествия
- Развлечения
- Ржач
- Семья
- Сериалы
- Спорт
- Стиль жизни
- ТВ передачи
- Танцы
- Технологии
- Товары
- Ужасы
- Фильмы
- Шоу-бизнес
- Юмор
Putin's Revenge, Part One (full documentary) | FRONTLINE
The inside story of Russian President Vladimir Putin’s conflict with the United States.
Subscribe on YouTube: http://bit.ly/1BycsJW
FRONTLINE tells the story of how Russian President Vladimir Putin came to see the United States as an enemy — and why he decided to target an American election. With in-depth reporting from Moscow and Washington, D.C., the team behind “The Choice 2016” examines Putin’s rise, rule and motivations.
Twitter: https://twitter.com/frontlinepbs
Facebook: https://www.facebook.com/frontline
Google+: https://plus.google.com/+frontline/posts
FRONTLINE is streaming more than 200 documentaries online, for free, here: http://to.pbs.org/hxRvQP
Funding for FRONTLINE is provided through the support of PBS viewers and by the Corporation for Public Broadcasting. Major funding for FRONTLINE is provided by the John D. and Catherine T. MacArthur Foundation and the Ford Foundation. Additional funding is provided by the Abrams Foundation, the Park Foundation, The John and Helen Glessner Family Trust, and the FRONTLINE Journalism Fund with major support from Jon and Jo Ann Hagler on behalf of the Jon L. Hagler Foundation.
Видео Putin's Revenge, Part One (full documentary) | FRONTLINE канала FRONTLINE PBS | Official
Subscribe on YouTube: http://bit.ly/1BycsJW
FRONTLINE tells the story of how Russian President Vladimir Putin came to see the United States as an enemy — and why he decided to target an American election. With in-depth reporting from Moscow and Washington, D.C., the team behind “The Choice 2016” examines Putin’s rise, rule and motivations.
Twitter: https://twitter.com/frontlinepbs
Facebook: https://www.facebook.com/frontline
Google+: https://plus.google.com/+frontline/posts
FRONTLINE is streaming more than 200 documentaries online, for free, here: http://to.pbs.org/hxRvQP
Funding for FRONTLINE is provided through the support of PBS viewers and by the Corporation for Public Broadcasting. Major funding for FRONTLINE is provided by the John D. and Catherine T. MacArthur Foundation and the Ford Foundation. Additional funding is provided by the Abrams Foundation, the Park Foundation, The John and Helen Glessner Family Trust, and the FRONTLINE Journalism Fund with major support from Jon and Jo Ann Hagler on behalf of the Jon L. Hagler Foundation.
Видео Putin's Revenge, Part One (full documentary) | FRONTLINE канала FRONTLINE PBS | Official
vladimir putin putin interview frontline putin's revenge frontline putin files putin russian speech putin russian anthem putin frontline documentary vladimir putin pbs documentary russia pbs documentary russia frontline documentary r putin documentary american elections us elections ukraine vs russia putin full documentary vladimir putin walk vladimir putin biography 2016 presidential election the choice 2016 frontline putin interviews
Комментарии отсутствуют
Информация о видео
8 февраля 2019 г. 23:35:00
00:53:08
Другие видео канала